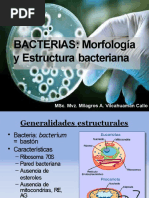
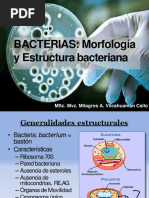

0% encontró este documento útil (0 votos)
90 vistas107 páginasMicro Clase 2 2023
El documento describe las características principales de las bacterias. Las bacterias son organismos unicelulares procariotas que carecen de organelos y tienen una pared celular. Se clasifican según su morfología (bacilos, cocos, formas helicoidales), composición de la pared celular (gram positivas, gram negativas) y nutrición (autótrofas, heterótrofas). La pared celular, membrana plasmática y citoplasma son las principales estructuras de las bacterias.
Cargado por
DIEGO JOSE ALENXANDRE SOSA VELAZQUEZDerechos de autor
© © All Rights Reserved
Nos tomamos en serio los derechos de los contenidos. Si sospechas que se trata de tu contenido, reclámalo aquí.
Formatos disponibles
Descarga como PPTX, PDF, TXT o lee en línea desde Scribd
0% encontró este documento útil (0 votos)
90 vistas107 páginasMicro Clase 2 2023
El documento describe las características principales de las bacterias. Las bacterias son organismos unicelulares procariotas que carecen de organelos y tienen una pared celular. Se clasifican según su morfología (bacilos, cocos, formas helicoidales), composición de la pared celular (gram positivas, gram negativas) y nutrición (autótrofas, heterótrofas). La pared celular, membrana plasmática y citoplasma son las principales estructuras de las bacterias.
Cargado por
DIEGO JOSE ALENXANDRE SOSA VELAZQUEZDerechos de autor
© © All Rights Reserved
Nos tomamos en serio los derechos de los contenidos. Si sospechas que se trata de tu contenido, reclámalo aquí.
Formatos disponibles
Descarga como PPTX, PDF, TXT o lee en línea desde Scribd